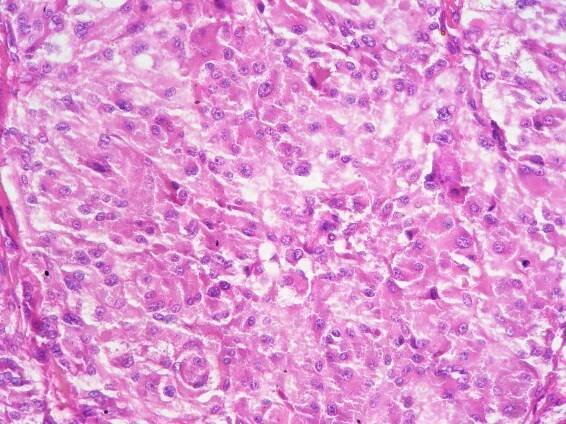
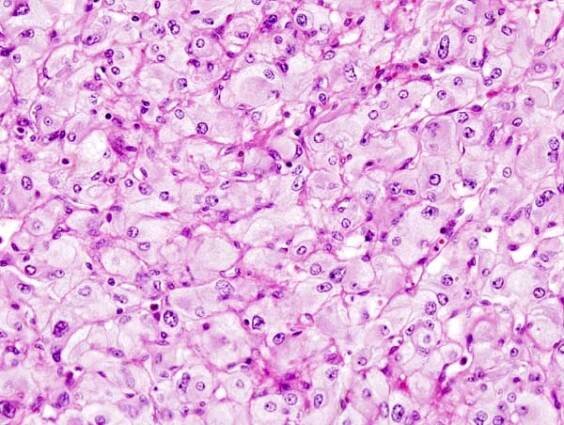

Feochromocytom je nádor, který se nachází v dřeni nadledviny (tj. ve středové části žlázy, která shora přiléhá k ledvině) a způsobuje nadměrnou tvorbu adrenalinu. Feochromocytomy jsou obvykle nezhoubné neboli benigní (tzn. nejedná se o rakovinu), ale mohou způsobovat vysoký krevní tlak, bolest hlavy,…
Feochromocytom – Wikipedie
Katecholaminy, které produkuje feochromocytom způsobují buď trvalou hypertenzi (vysoký krevní tlak), popřípadě epizody nebo záchvaty vážné hypertenze.
Feochromocytom | frequenz-therapie.com
Pokud se feochromocytom podařilo zcela odstranit chirurgickým zákrokem , je prognóza obvykle příznivá. Ve většině případů se po operaci krevní tlak normalizuje a příznaky zmizí.
Feochromocytom | Medicína, nemoci, studium na 1. LF UK
Feochromocytom je zajímavý typ nádoru nadledvin, který vychází z jejich dřeně. Většinou je nezhoubný (někdy však může být i zhoubný a vytvářet metastázy), ale přesto může ohrožovat nemocného na životě.
Feochromocytom - Pacák, Karel - Megaknihy.cz
Laboratorní diagnostika feochromocytomu | Digitální repozitář…
Feochromocytom způsobuje zvýšení hladiny vyplavovaných katecholaminů, což může mít v neléčených případech fatální důsledky.
Kniha Feochromocytom | Odborná literatura a právnická…
Kniha Feochromocytom, Pacák Karel, Feochromocytomy jsou vzácné, ale zrádné nádory dřeně nadledvin, které produkují katecholaminy ...
Cena 490 KčSkladem
Feochromocytom – proč je jeho časná diagnóza pro p…
Autoři: Tomáš Zelinka; Jiří Widimský Jr Působiště autorů: Centrum pro výzkum, diagnostiku a léčbu hypertenze III. interní kliniky – kliniky endokrinologie a metabolizmu 1. LF UK a VFN Praha, přednosta prof.
Interní Med.: Feochromocytom
Feochromocytomy jsou vzácné neuroendokrinní nádory s velmi proměnlivými klinickými projevy, pro nějž jsou typické záchvatovité obtíže – bolesti hlavy, pocení, palpitace a hypertenze.
Feochromocytom je nádor z chromafinních buněk produkujících katecholaminy, které vyvolávají hypertenzi. Katecholaminy, které produkuje feochromocytom způsobují buď trvalou hypertenzi (vysoký krevní tlak), popřípadě epizody nebo záchvaty vážné hypertenze. Dalšími příznaky nadměrné produkce katecholaminů jsou bolesti hlavy, bušení srdce, pocení, nevolnost, úzkost a… Wikipedie
odkazuje na služby nejen od Seznam.cz.
© 1996–2025 Seznam.cz, a.s.